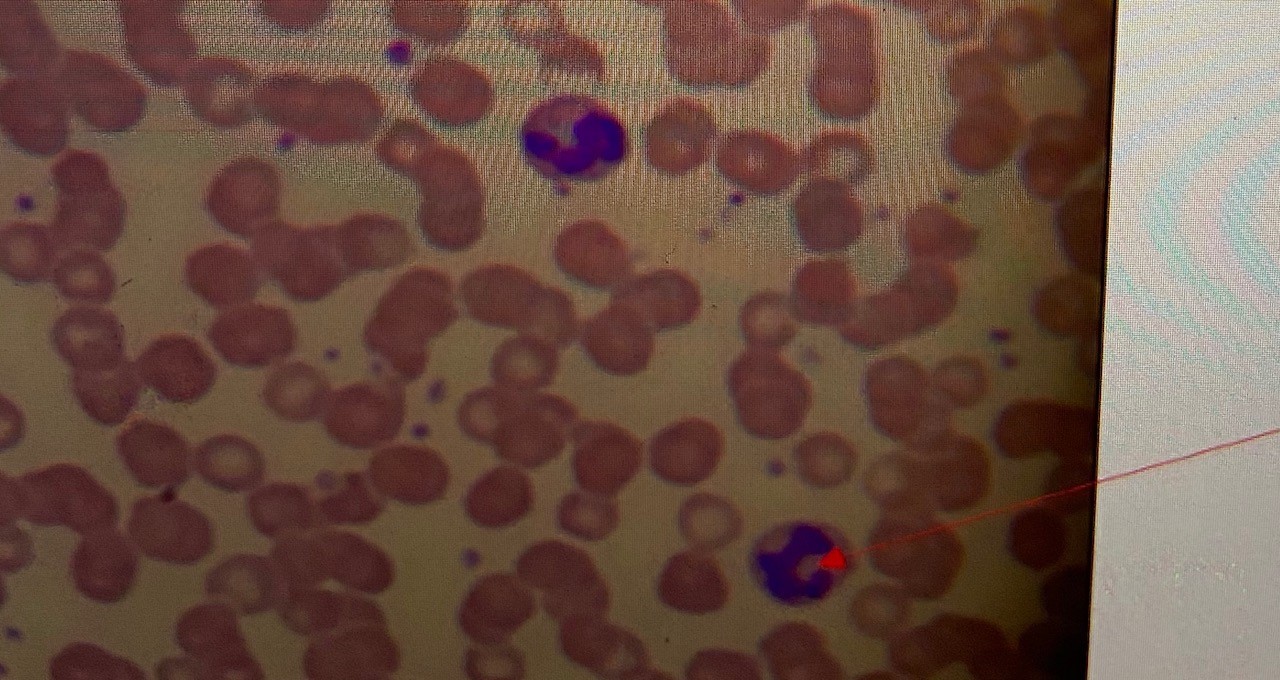

Identify the entire circular unit.

osteon
Identify the specific bone seen at the tip of the blue arrow.

ilium
Identify the opening seen at the tip of the red arrow.

supraorbital foramen
What is the view of this bone?

posterior
Identify the depression seen at the tip of the arrow.

sella turcica
INCORRECT
Identify the opening seen at the tip of the red arrow.

obturator foramen
Identify the structure (space) at the tip of the blue arrow.

medullary cavity
Identify the specific bone seen at the tip of the blue arrow.
(full labeling is required)

4th middle phalanx
Identify the epening at the tip of the red arrow.

mental foramen
Identify the specific tissue seen here.

skeletal muscle
Identify the plane of section labeled #20 seen at the tip of the black arrow.

parasagittal section
Name a location in the body of the tissue seen here.

lining of stomach
INCORRECT
Identify the area labeled #21 seen at the tip of the black arrow.
(left or right required)

right iliac region
Name the specific tissue type seen here.

stratified squamous epithelium
Identify the area labeled #22 seen at the tip of the black area.
(right or left required; no abbreviations)

left upper quadrant
INCORRECT
Name a location in the body for the tissue seen here.

epiglottis
Identify the bone seen at the tip of the blue arrow.

navicular
Identify the structure at the tip of the red arrow.

central canal
Identify the cell at the tip of the red arrow.
leukocyte
Identify the region labeled #25 seen at the tip of the black arrow.

popliteal
Identify the cell seen here.

sperm
Identify the bone seen at the tip of the red arrow.

occipital bone
INCORRECT
Name the specific tissue type seen here.

fibrocartilage
Identify the structure labeled #27 seen at the tip of the black arrow.

lysosome